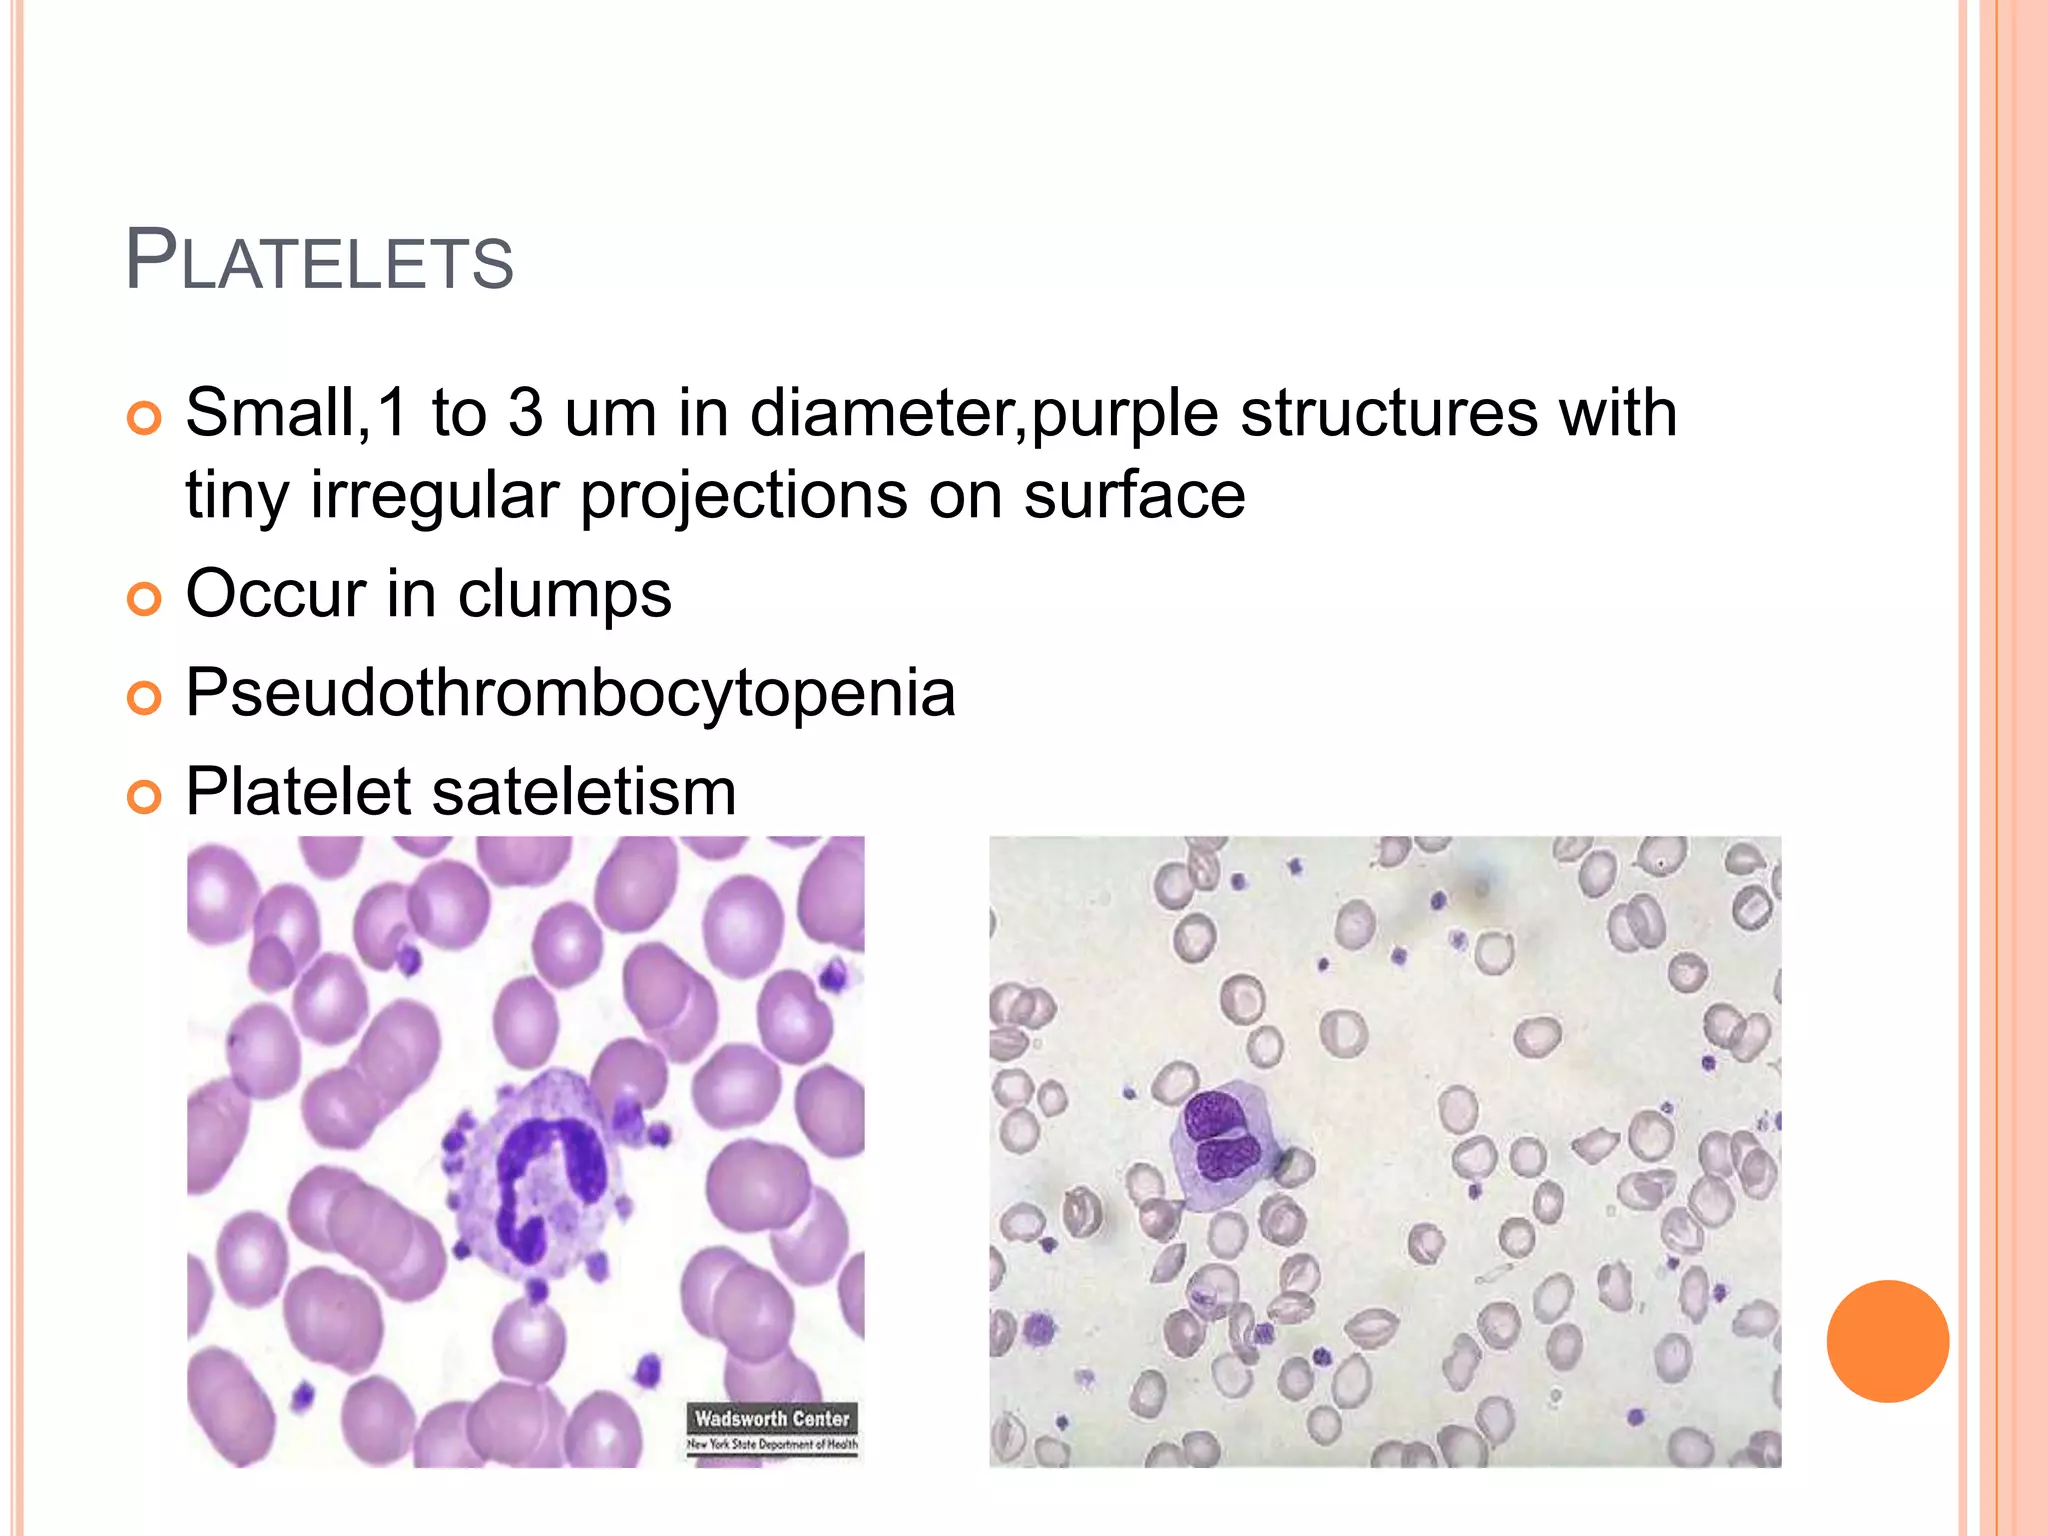
PLATELETS
 Small,1 to 3 um in diameter,purple structures with
tiny irregular projections on surface
 Occur in clumps
 Pseudothrombocytopenia
 Platelet sateletism

This document discusses total leukocyte count and differential counting. It describes the types of white blood cells including granulocytes (neutrophils, eosinophils, basophils) and agranulocytes (lymphocytes, monocytes). The procedure for a total leukocyte count involves diluting a blood sample and counting cells under a microscope. A differential count identifies percentages of each type of white blood cell by examining stained blood smears under oil immersion lens. Normal ranges and abnormal findings are also outlined.